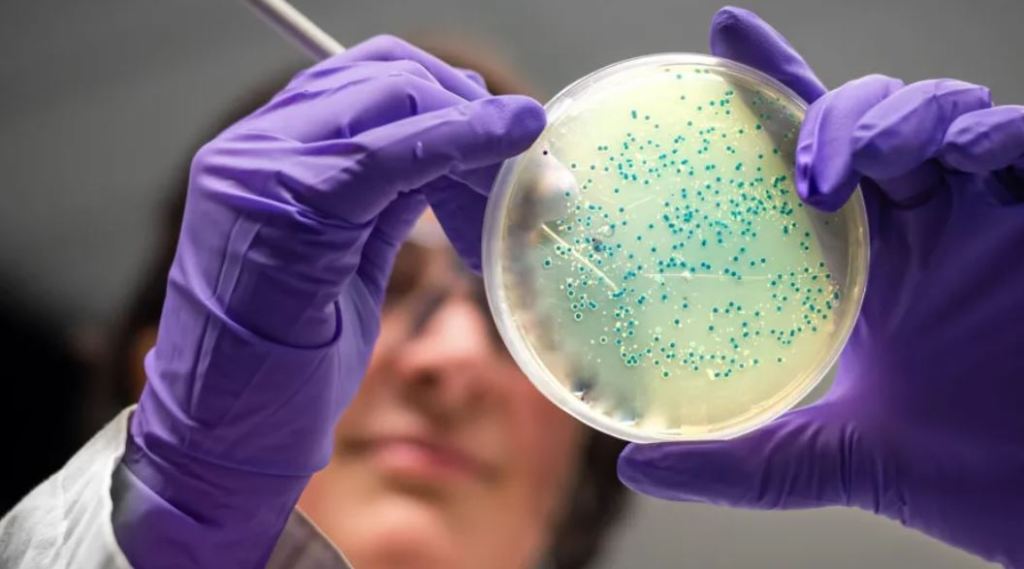

There is hardly a more salient topic today than how artificial intelligence will transform our future, and how it is already transforming our present. Comparatively little has been written, however, on how AI exacerbates several negative and concerning societal trends that stem from our past.
Much has been written about how AI represents technological “progress.” To this I undoubtedly concur. It certainly sets the stage for the greatest feats and challenges of the 21st century; all great scientific achievements, national security risks, and energy innovations will undoubtedly intersect with the capabilities and needs of AI. For instance, in just the past week of my writing, AI designed new potential antibiotics for longtime medicine-resistant killers like MRSA.
AI has been used to design potential and long-awaited antibiotics for some diseases.
Source: BBC News / Getty Images
This, I feel, is a use for AI that most people could agree with, because in this regard AI acts like any other tool: as an extension of ourselves. Scientists have long sought new antibiotic drugs through research, experimentation, and trial by error. They have also for many years used computing technologies designed to assist them in simulations and data gathering that bring useful information to their attention, from which they can synthesize and perform a judgement upon.
Notice that here technology, whether AI or a regular computer program, is merely a helper assisting humans in the search for answers; it brings them information from which they can use in their pursuit of an end. When I type on a computer to write instead of using a pen and paper, it serves as an extension of myself by allowing me to type and revise errors faster. Notably, it is still I who is doing the thinking and writing and applying judgement to what is written. I am aware of Wendell Berry’s excellent essay Feminism, the Body, and the Machine, where he (justly) lambasts computer word processing in favor of the more traditional means. But alas, typing is all I have ever known, and though I wish I could, I cannot relate to the fulfillment of his experience hand-writing.
I posit that there is a line to be crossed whereby technology’s helpfulness shifts to a hindrance. But pinpointing this line requires an examination of what is truly helpful or useful to a human being. We must ask ourselves, is it possible to be so helpful as to in fact be a detriment?
This is certainly a sentiment apparent in folk culture. All are familiar with the Taoist parable “give a man a fish and you feed him for a day. Teach him how to fish and you feed him for a lifetime.” For parents, teachers, and friends alike, we tend to believe that to be helpful one must impart a character or skill that will mold a person into someone who is useful. But usefulness understood as such is reflexive; it involves a degree of self-sufficiency. We wish to form the person into someone useful to others by making him useful to himself. In this conception of usefulness, removing self-sufficiency, such as when we simply do the work for them (“give a man a fish”) instead of teaching them (“teach him how to fish”), is the opposite of being helpful.
Most Americans instinctively sense this in a multitude of private and societal matters. Take, for instance, the “social safety net.” Although the size and frequency of welfare payments are hotly debated between conservatives and liberals, both sides strongly emphasize the need for personal development and career training programs to help the disadvantaged begin to earn their own money and succeed on their own two feet. Most Americans intuitively realize what statistics unquestioningly affirm: that many of those suffering in the most grinding poverty were raised in broken families that did not impart the character or skills that could develop them into one useful to themself or others.
Self-made success stories never fail to move our hearts: the homeless man regularly begging on the street who was finally able to hold a job and move into a home, the child who overcame the adversity of her broken home through hard work and character–we instinctively see the beauty and romance in such a struggle and victory. In my home state such a story has motivated voters to the polls for a generation, enabling Senator Tim Scott to become the longest serving black senator in US history, and the first from the South since the Reconstruction.

South Carolina Senator Tim Scott’s moving story of triumph over adversity is beloved by his constituents. Source: Bloomberg via Getty Images / ABC News
Now consider the alternative. Each of us knows a bratty child who has had everything done for them their whole life, and how useless of an adult they become. Notably, with no skills and shoddy character they are useless to themselves, and through this personal uselessness they remain always dependent on a spouse or a parent–and are therefore useless to others. Or recall the project partner in high school who would never do their side of the work, always leaving it to you. Their uselessness to themself, reflected in their poor grades, automatically also became a uselessness to you, who now must do double the work.
If we feel pride at individual success and self-sufficiency and bitterness towards the lazy who hardly lift a finger, then why is our collective society so eager to utilize artificial intelligence in ways which move beyond helpfulness, ways which promise to destroy our uniquely human capacity for self-sufficiency by thinking, writing, and deciding for us–leaving us no other skill beyond what it takes to type a prompt at the bottom of a screen?
In fact, consider the irony of that common quip for a lazy individual: he barely lifted a finger. Why, with AI, barely lifting a finger is all that is needed now! One must simply type a prompt!
When AI is utilized to read, write, and think for us, it is being used in a materially different way than the antibiotic example referenced above. No longer is the program a means to an end. No more does it simply reduce barriers to obtaining useful information upon which an individual can apply their reasoning and judgement to accomplish an end. No, much of AI’s marketing and adoption is for it to reach the end for us.
“But summarizing a report, deciding between several choices, and writing an email (to take a handful of examples from recent tech commercials) is a way of lowering the barrier to obtaining the information I need to do my job,” one may protest to me. Is that so? In a typical workday, if AI is used to synthesize your reading, decide for you what choice to make in light of it, and then write the email that contains your decision to your superiors, where does this leave you in the work of the day? Does merely tweaking some words around in the final product (an excuse I hear all too often) really make it yours? The way I grew up, that was called plagiarism.
As Austin Hoffman writes in his excellent article Artificial Intelligence for the Artificially Intelligent, “If the president or CEO can outsource all of his emails, communications, and decisions to a robot, what are you really paying him for?…AI reveals who works as a human and provides irreplaceable value and who was operating as a dispensable cog performing meaningless busywork all along.”

Will we allow artificial intelligence to reduce the dignity of work into merely typing a prompt?
Source: Medium
Moreover, the above frame of questioning only truly applies to adults who are experiencing the AI revolution now in the middle of their careers and who are therefore able to choose between using AI versus using their “traditional” skills when debating how to integrate it into their daily tasks. But this line of thinking does not apply at all to the next generation. What about the child who will grow up using this technology and not know any other way? Recall my computer vs. hand-writing example above, although I learned how to write by hand it was never practiced–and so I do not know the pleasures of handwriting as Wendell Berry does in any higher sense of the term. Raised on computer technology, hand writing is instead for me a chore.
Therefore I ask: do we really want to raise a generation for which the act of thinking itself becomes a chore?
And so I come to the crux of my argument. The swift adoption of AI in ways that atrophy or replace the “human arts” reveal just how far our societal conception of usefulness has changed. It portrays just how intrusively the utilitarian thought of the 19th century and corporate capitalism, which declare efficiency and profit to be a good above all others, has wriggled its way into our collective consciousness.
We used to think of usefulness in terms of what has been imparted to a person in a moral sense, how they have been molded for their own success. Now we only think of what is useful mechanistically, as what saves the most time. Consider the examples I have used throughout this essay; in such a utilitarian frame, what does an employer care if your lackadaisical partner does not put in their share of the work and you must complete it for them? Even if you work a double portion to complete a project, the same number of man-hours has still been worked. From this perspective, the project is still completed in the same amount of time, though the partner will fail when called upon to accomplish the task alone.
Now, if a technology that can read, write, and decide for both you and your partner has suddenly appeared–one that can reduce the man-hours dedicated outright, a utilitarian employer concerned about nothing more than his bottom line would be a fool to reject its adoption. Though this effectively transforms the usefulness of the modern worker into his status as a bag of flesh who for the time being is needed to type a prompt into a chatbot while such a thing still remains necessary. Oh the inefficiency of inefficiencies, how they await the day when even our ability to type a prompt becomes obsolete!
“But we must adopt it, to compete!” Indeed you must, and I do sympathize with leaders who recognize the inhumanity of our time but feel trapped in this way. For AI’s adoption runs in parallel with the most detrimental consequence of capitalism–by transforming all things into markets, by allowing the pursuit of money above all else, we are drug into a universal competition that we cannot escape, for fear that the consequence of “losing” be worse than that of whatever sins we must commit along the way. Our politicians certainly try to make us believe this, at least.
In such a competition, what is objectively right or wrong does not matter, all that matters is that we “beat”–a poorly defined term if there ever was one–our adversaries or the world as we know it will end. We are reaping what we have sowed, the amoral sentiment of Thrasymachus, that “justice is the advantage of the stronger.”

Plato, whose character Thrasymachus engaged in a battle of mind with Socrates. Source: iep.edu
I believe that this is the key of the AI debate. Facts cannot be separated from morality; their very application in relation to the circumstances of a situation is what makes a decision right or wrong. Social and political life is one that is necessarily moral, because it involves relations and interactions that are ordered by their obligations and their proximity to us as individuals. But artificial intelligence, which by definition takes a mechanistic approach to “judgement,” does not take morality into account. Both the adoption and the process of AI apply the same mechanistic, technocratic ‘judgement’ that does not take morality into account, furthering the inhuman utilitarianism of our age.
I could not put it better than scholar Tony Mills, who wrote in The Role of Judgment and Deliberation in Science-Based Policy, “Science illuminates, rather than eliminates, the need for judgment and deliberation”
So I implore my readers, recognize the distinction between AI when used as something truly useful in the human pursuit of an end, versus something that merely usurps that end from us. Resist and fight the utilitarian impulse to use AI in this way, for the sake of your self-sufficiency and that of our children.
By Evan Patrohay


Leave a comment